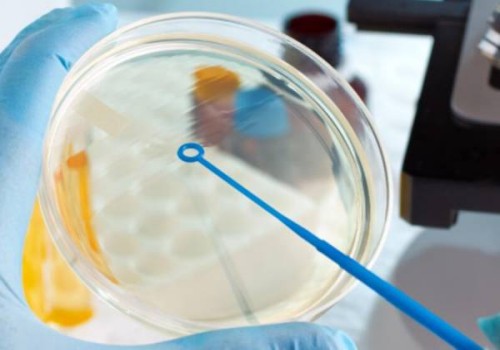

联系方式
CONTACT INFO
广州试管助孕价格:这些食物有助于卵泡发育,也就是有助于怀孕!
备孕期间有许多需要注意的事项,比如多吃促进卵泡发育的食物,如果卵泡发育不正常,会导致卵子无法正常排出,精子自然不能与卵子受精,从而导致受孕失败。平时要多注意饮食,可以多吃蜂王浆、豆制品、火龙果、柠檬等,备孕期间多食用可以提高怀孕概率。
促进卵泡发育的八大食物
1、火龙果
火龙果里面微量元素与维生素,对卵泡发育有很大好处,另外,火龙果尽量选择新鲜的,如果不喜欢直接吃,可以将火龙果榨成果汁,或者做成水果沙拉,味道还是不错的。
2、柠檬
柠檬不仅可以促进卵泡发育,还能改善皮肤,柠檬里面还含有少量的矿物质,比如铁、锌等元素,经常食用可以满足身体需求。柠檬的味道有些酸,可以将柠檬泡水喝,或者榨成柠檬汁。
3、豆制品
一些调查结果显示,豆制品里面含有丰富的植物雌激素,比如黄豆、黑豆、红豆等,经常食用豆制品可以促进卵泡发育。如果不喜欢吃黄豆或者黑豆,可以吃豆腐、豆干、豆泡、豆浆等,效果都是一样的。
4、蜂王浆
经常食用蜂王浆也可以促进卵泡发育,特别是新鲜的蜂王浆,可以促进卵泡发育,每天起床用一勺蜂王浆泡水喝,不仅可以调节内分泌,还能补充身体所需营养。
5、水鱼汤
食用水鱼汤时最好在月经后的第五天,炖水鱼汤时可以放入山芋、枸杞、当归等,炖的时候最好
6、松露
松露的营养价值比较丰富,不仅含有多种微量元素,还富含丰富的蛋白质,非常适合备孕期的女性食用,可以促进卵泡发

7、生姜红糖水
生姜红糖水有活血与暖宫的效果,每次月经来临时都可以喝生姜红糖水,可以改善卵泡发育问题。
8、糯米粥
女性排卵期可以喝糯米粥,熬煮糯米粥可以放入一些红糖,对身体有很大好处。
促进卵泡发育的注意事项
1、心情
卵泡发育期间要保持心情愉悦,以免内分泌失调,心情不好时可以出门走一走,或者与朋友聊聊天,放松一下心情。
2、禁止吸烟喝酒
经常吸烟喝酒会影响卵泡的发育,备孕期应禁烟禁酒,养成好的生活习惯,这样不仅有利于身体健康,还可以保证卵泡发育健康。